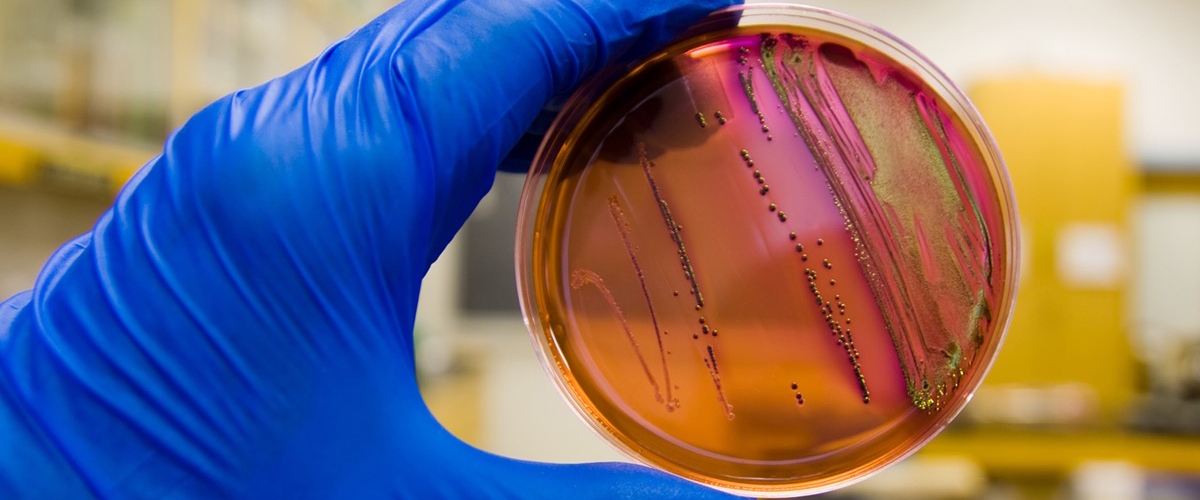
image

Новый антибиотик фабимицин победил более 300 устойчивых к лекарствам бактерий
Что, если я скажу вам, что учёные, возможно, нашли ключ к одной из самых страшных проблем современной медицины? Исследователи из Американского химического общества представили новую молекулу — фабимицин. В лабораторных испытаниях она справилась с более чем 300 видами бактерий, которые научились игнорировать обычные антибиотики. Похоже на прорыв, не так ли?
А проблема-то глобальная. Всемирная организация здравоохранения давно бьёт тревогу: устойчивость к антибиотикам — одна из главных угроз человечеству. Поэтому каждая такая новость — это глоток воздуха в буквальном смысле, ведь речь идёт о спасении миллионов жизней.
В основе фабимицина лежит уже известный антибиотик, который раньше работал только против одного типа бактерий (грамположительных). Учёные его «перекроили», внеся структурные изменения. И вуаля — соединение получило пропуск в мир грамотрицательных бактерий. Эти штаммы — настоящие кошмары современных больниц, виновники тяжёлых пневмоний и заражений крови. И они научились отбиваться практически от всего.
Но фабимицин, судя по всему, их обманул. На мышах, заражённых устойчивыми инфекциями мочевыводящих путей и лёгких, препарат показал себя блестяще. В некоторых случаях он даже превзошёл по эффективности стандартные лекарства, снизив количество бактерий до исходного, «здорового» уровня. Вы только вдумайтесь: до уровня до заражения!
Теперь авторы работы с осторожным оптимизмом надеются, что их детище станет новым оружием в борьбе с неуязвимыми инфекциями. Конечно, впереди долгий путь клинических испытаний на людях. Но начало более чем многообещающее.
И это исследование — часть большой тенденции. Недавно, к примеру, другие учёные создали инструмент, предсказывающий, когда бактерия туберкулёза станет устойчивой к лекарствам. Наука больше не хочет играть в догонялки с инфекциями. Она пытается заглянуть вперёд и перехитрить их. А вы как думаете, у нас получится?










